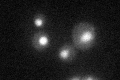
YNL245C
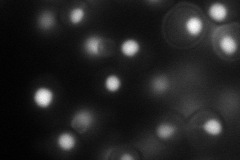
YNL245C
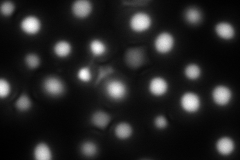
YNL245C
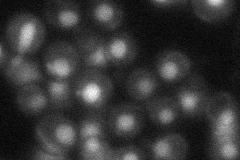
YNL245C

View description
Heat-stable protein required for the first step of pre-mRNA splicing; component of a complex containing Cef1p; has similarity to S. pombe Cwf25p
Localization:
Intensity:
Fold change:
Significance:
-
C’ GFP library in SD
nucleus34.14 -
N' NOP1pr-GFP in SD
nucleus92.7197 -
N' TEF2pr-mCherry in SD
nucleus166.311 -
N' NATIVEpr-GFP in SD
nucleus34.9153 -
N' TEF2pr-VC and Cyto-VN in SD

nucleus42.0515 -
C’ GFP library in SD+DTT

nucleus29.970.87No -
C’ GFP library in SD+H2O2

nucleus27.210.79No -
C’ GFP library in Starvation Media

nucleus20.260.59Yes -
C’ GFP library on the background of Pup2-DaMP

nucleus -
C’ GFP library on the background of CCT mutant

nucleus29.73330.870791No
